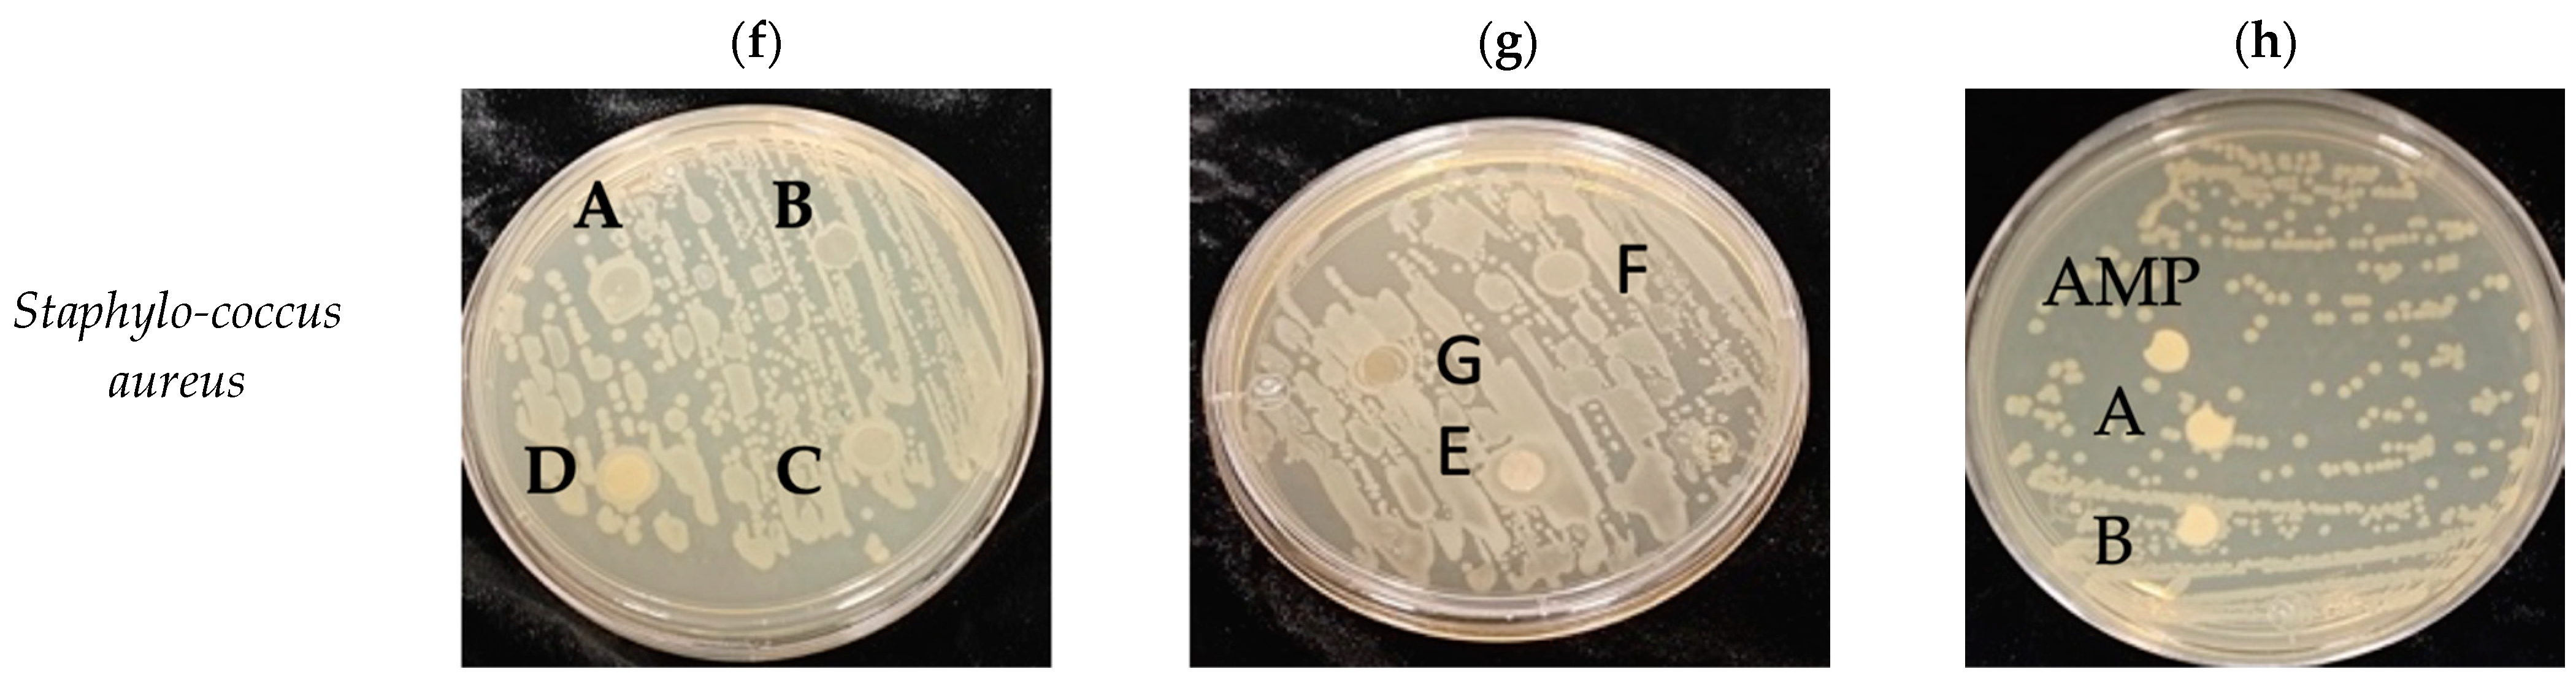
Polymers 15 03793 g009b

Thermoplastic Starch Biocomposite Films Reinforced with Nanocellulose from Agave tequilana Weber var. Azul Bagasse
Abstract
:1. Introduction
2. Materials and Methods
2.1. Materials
2.2. Preparation of Agave Alkaline Pulp
2.3. Chlorine-Free Pulp Bleaching
Scanning Electron Microscopy (SEM)
2.4. Cellulose Nanofibrils Isolation and Characterization
2.5. Cellulose Nanocrystals Preparation
2.6. Atomic Force Microscope (AFM)
2.7. Starch and Biocomposites Films Preparation
2.8. Characterization of Biocomposites Films
2.8.1. Color Analysis, Crystallinity, X-ray Diffraction and Electrical Conductivity
2.8.2. Solubility and Water Vapor Permeability
2.8.3. Fourier-Transform Infrared Spectroscopy (FTIR-ATR)
2.8.4. Differential Scanning Calorimetry (DSC) and Thermogravimetric Analysis (TGA)
2.8.5. Mechanical Properties
2.8.6. Scanning Electron Microscope (SEM) and Rugosity
2.8.7. Antibacterial Properties
2.9. Statistical Analysis
3. Results and Discussion
3.1. Preparation of Agave Pulp
3.2. Characterization of Agave Fibers
3.3. CNCs Isolation and Characterization
3.4. Starch and Biocomposites Films Preparation and Characterization
3.5. Solubility and Water Vapor Permeability
3.6. Fourier-Transform Infrared Spectroscopy (FTIR)
3.7. Differential Scanning Calorimetry (DSC) and Thermogravimetric Analysis (TGA)
3.8. Mechanical Properties
3.9. Morphology of Thermoplastic Starch and Biocomposite Films
3.10. Antimicrobial Properties
3.11. Potential Application of Film Composites
4. Conclusions
Supplementary Materials
Author Contributions
Funding
Institutional Review Board Statement
Informed Consent Statement
Data Availability Statement
Acknowledgments
Conflicts of Interest
References
- Cazón, P.; Velazquez, G.; Ramírez, J.A.; Vázquez, M. Polysaccharide-based films and coatings for food packaging: A review. Food Hydrocoll. 2017, 68, 136–148. [Google Scholar] [CrossRef]
- Lomelí-Ramírez, M.G.; Barrios-Guzmán, A.J.; García-Enriquez, S.; de Jesús Rivera-Prado, J.; Manríquez-González, R. Chemical and mechanical evaluation of bio-composites based on thermoplastic starch and wood particles prepared by thermal compression. BioResources 2014, 9, 2960–2974. [Google Scholar] [CrossRef]
- Mali, S.; Grossmann, M.V.E.; Garcia, M.A.; Martino, M.N.; Zaritzky, N.E. Microstructural characterization of yam starch films. Carbohydr. Polym. 2002, 50, 379–386. [Google Scholar] [CrossRef]
- Satyanarayana, K.G.; Arizaga, G.G.C.; Wypych, F. Biodegradable composites based on lignocellulosic fibers-An overview. Prog. Polym. Sci. 2008, 34, 982–1021. [Google Scholar] [CrossRef]
- James, M.; Myers, A. Seed starch synthesis. In Handbook of Maize: Its Biology; Bennetzen, J., Hake, S., Eds.; Springer: New York, NY, USA, 2009; pp. 439–456. [Google Scholar] [CrossRef]
- Rindlav-Westling, Å.; Stading, M.; Gatenholm, P. Crystallinity and morphology in films of starch, amylose and amylopectin blends. Biomacromolecules 2002, 3, 84–91. [Google Scholar] [CrossRef]
- Fredriksson, H.; Silverio, J.; Andersson, R.; Eliasson, A.C.; Åman, P.J.C.P. The influence of amylose and amylopectin characteristics on gelatinization and retrogradation properties of different starches. Carbohydr. Polym. 1998, 35, 119–134. [Google Scholar] [CrossRef]
- Patil, N.V.; Netravali, A.N. Nonedible starch based “green” thermoset resin obtained via esterification using a green catalyst. ACS Sustain. Chem. Eng. 2016, 4, 1756–1764. [Google Scholar] [CrossRef]
- Xu, H.; Canisag, H.; Mu, B.; Yang, Y. Robust and flexible films from 100% starch cross-linked by biobased disaccharide derivative. ACS Sustain. Chem. Eng. 2015, 3, 2631–2639. [Google Scholar] [CrossRef]
- Bertolini, A. Starches: Characterization, Properties, and Applications, 1st ed.; Taylor & Francis Group: Oxfordshire, UK, 2017. [Google Scholar]
- Ma, X.; Chang, P.R.; Yu, J.; Stumborg, M. Properties of biodegradable citric acid-modified granular starch/thermoplastic pea starch composites. Carbohydr. Polym. 2009, 75, 1–8. [Google Scholar] [CrossRef]
- Reddy, N.; Yang, Y. Citric acid cross-linking of starch films. Food Chem. 2010, 118, 702–711. [Google Scholar] [CrossRef]
- Xie, F.; Pollet, E.; Halley, P.J.; Avérous, L. Starch-based nano-biocomposites. Prog. Polym. Sci. 2013, 38, 1590–1628. [Google Scholar] [CrossRef]
- Huang, L.; Zhao, H.; Yi, T.; Qi, M.; Xu, H.; Mo, Q.; Chongxing, H.; Shuangfei, W.; Liu, Y. Preparation and properties of cassava residue cellulose nanofibril/cassava starch composite films. Nanomaterials 2020, 10, 755. [Google Scholar] [CrossRef] [PubMed]
- Consejo Regulador del Tequila. (n.d.). Available online: https://www.crt.org.mx/EstadisticasCRTweb/ (accessed on 1 December 2021).
- Huitrón, C.; Pérez, R.; Sánchez, A.; Lappe, P.; Zavaleta, L.R. Agricultural waste from the tequila industry as substrate for the production of commercially important enzymes. J. Environ. Biol. 2008, 1, 37–41. [Google Scholar]
- Gallardo-Sánchez, M.A.; Hernández, J.A.; Casillas, R.R.; Vázquez, J.I.E.; Hernández, D.E.; Martínez, J.F.A.S.; Enríquez, S.G.; Balleza, E.R.M. Obtaining Soluble-grade cellulose pulp from Agave tequilana Weber var. Azul Bagasse. BioResources 2019, 14, 9867–9881. [Google Scholar] [CrossRef]
- Ponce-Reyes, C.E.; Chanona-Pérez, J.J.; Garibay-Febles, V.; Palacios-González, E.; Karamath, J.; Terrés-Rojas, E.; Calderón-Domínguez, G. Preparation of cellulose nanoparticles from agave waste and its morphological and structural characterization. Rev. Mex. Ing. Química 2014, 13, 897–906. Available online: https://www.scielo.org.mx/scielo.php?script=sci_isoref&pid=S1665-27382014000300021&lng=es&tlng=en (accessed on 15 May 2023).
- Gallardo-Sánchez, M.A.; Diaz-Vidal, T.; Navarro-Hermosillo, A.B.; Figueroa-Ochoa, E.B.; Casillas, R.R.; Hernández, J.A.; Rosales-Rivera, L.C.; Martínez, J.F.A.S.; Enríquez, S.G.; Macías-Balleza, E.R. Optimization of the obtaining of cellulose nanocrystals from Agave tequilana weber var. Azul Bagasse by acid hydrolysis. Nanomaterials 2021, 11, 520. [Google Scholar] [CrossRef] [PubMed]
- Pech-Cohuo, S.C.; Canche-Escamilla, G.; Valadez-González, A.; Fernández-Escamilla, V.V.A.; Uribe-Calderon, J. Production and Modification of Cellulose Nanocrystals from Agave tequilana Weber Waste and Its Effect on the Melt Rheology of PLA. Int. J. Polym. Sci. 2018, 2018, 3567901. [Google Scholar] [CrossRef]
- Jiménez-Amezcua, R.; Villanueva-Silva, J.R.; Muñoz-García, R.O.; Macias-Balleza, R.; Sydenstricker Flores-Sahagún, H.M.T.; Lomelí-Ramírez, M.G.; Garcia-Enriquez, S. Preparation of Agave tequilana Weber Nanocrystalline Cellulose and its Use as Reinforcement for Acrylic Hydrogels. BioResources 2021, 16, 2731–2746. [Google Scholar] [CrossRef]
- Palacios-Hinestroza, H.; Hernández-Diaz, J.A.; Esquivel-Alfaro, M.; Toriz, G.; Rojas, O.J.; Sulbarán-Rangel, B.C. Isolation and Characterization of Nanofibrillar Cellulose from Agave tequilana Weber Bagasse. Adv. Mater. Sci. Eng. 2019, 2019, 1342547. [Google Scholar] [CrossRef]
- Robles-García, M.Á.; Del-Toro-Sánchez, C.L.; Márquez-Ríos, E.; Barrera-Rodríguez, A.; Aguilar, J.; Aguilar, J.A.; Reynoso-Marín, F.J.; Ceja, I.; Dórame-Miranda, R.; Rodríguez-Félix, F. Nanofibers of cellulose bagasse from Agave tequilana Weber var. azul by electrospinning: Preparation and characterization. Carbohydr. Polym. 2018, 192, 69–74. [Google Scholar] [CrossRef]
- Martínez-Salcedo, S.L.; Torres-Rendón, J.G.; García-Enriquez, S.; Anzaldo-Hernández, J.; Silva-Guzmán, J.A.; de Muniz, G.I.B.; Lomelí-Ramírez, M.G. Physicomechanical characterization of poly (acrylic acid-co-acrylamide) hydrogels reinforced with TEMPO-oxidized blue agave cellulose nanofibers. Fibers Polym. 2022, 23, 1161–1170. [Google Scholar] [CrossRef]
- Grishkewich, N.; Mohammed, N.; Tang, J.; Tam, K.C. Recent advances in the application of cellulose nanocrystals. Curr. Opin. Colloid Interface Sci. 2017, 29, 32–45. [Google Scholar] [CrossRef]
- Phanthong, P.; Reubroycharoen, P.; Hao, X.; Xu, G.; Abudula, A.; Guan, G. Nanocellulose: Extraction and application. Carbon Resour. Convers. 2018, 1, 32–43. [Google Scholar] [CrossRef]
- Slavutsky, A.M.; Bertuzzi, M.A. Water barrier properties of starch films reinforced with cellulose nanocrystals obtained from sugarcane bagasse. Carbohydr. Polym. 2014, 110, 53–61. [Google Scholar] [CrossRef] [PubMed]
- Silva, A.P.M.; Oliveira, A.V.; Pontes, S.M.A.; Pereira, A.L.S.; Filho, M.d.S.M.S.; Rosa, M.F.; Azeredo, H.M.C. Mango kernel starch films as affected by starch nanocrystals and cellulose nanocrystals. Carbohydr. Polym. 2019, 211, 209–216. [Google Scholar] [CrossRef] [PubMed]
- Huang, L.; Xu, H.; Zhao, H.; Xu, M.; Qi, M.; Yi, T.; An, S.; Zhang, X.; Li, C.; Huang, C.; et al. Properties of thermoplastic starch films reinforced with modified cellulose nanocrystals obtained from cassava residues. New J. Chem. 2019, 43, 14883–14891. [Google Scholar] [CrossRef]
- Kwaśniewska, A.; Chocyk, D.; Gładyszewski, G.; Borc, J.; Świetlicki, M.; Gładyszewska, B. The influence of kaolin clay on the mechanical properties and structure of thermoplastic starch films. Polymers 2020, 12, 73. [Google Scholar] [CrossRef]
- Metzger, C.; Briesen, H. Thermoplastic Starch Nanocomposites Reinforced with Cellulose Nanocrystal Suspensions Containing Residual Salt from Neutralization. Macromol. Mater. Eng. 2021, 306, 2100161. [Google Scholar] [CrossRef]
- Fazeli, M.; Keley, M.; Biazar, E. Preparation and characterization of starch-based composite films reinforced by cellulose nanofibers. Int. J. Biol. Macromol. 2018, 116, 272–280. [Google Scholar] [CrossRef]
- Rivadeneira-Velasco, K.E.; Utreras-Silva, C.A.; Díaz-Barrios, A.; Sommer-Márquez, A.E.; Tafur, J.P.; Michell, R.M. Green nanocomposites based on thermoplastic starch: A review. Polymers 2021, 13, 3227. [Google Scholar] [CrossRef]
- Dodervic, D.; Necasova, L.; Antonic, B.; Jancikova, S.; Tremlova, B. Plastic Cutlery Alternative: Case Study with Biodegradable Spoons. Foods 2021, 10, 1612. [Google Scholar] [CrossRef]
- TAPPI T236 om-22; Kappa Number of Pulp. STANDARD by Technical Association of the Pulp and Paper Industry. Tappi Press: Atlanta, GA, USA, 2022.
- TAPPI T230 om-19; Viscosity of Pulp (Capillary Viscometer Method). STANDARD by Technical Association of the Pulp and Paper Industry. Tappi Press: Atlanta, GA, USA, 2019.
- TAPPI T 203 cm-22; Alpha-, Beta- and Gamma-Cellulose in Pulp. STANDARD by Technical Association of the Pulp and Paper Industry. Tappi Press: Atlanta, GA, USA, 2022.
- Ramírez Casillas, R.; López López, M.d.C.; Becerra Aguilar, B.; Dávalos Olivares, F.; Gundappa Satyanarayana, K. Preparation and Characterization of Cellulose Nanocrystals using Soluble Grade Cellulose from Acid Hydrolysis of Huizache (Acacia farnesiana L. Willd.). BioResources 2019, 14, 3319–3338. [Google Scholar] [CrossRef]
- Jaramillo, C.M.; González Seligra, P.; Goyanes, S.; Bernal, C.; Famá, L. Biofilms based on cassava starch containing extract of yerba mate as antioxidant and plasticizer. Starch–Stärke 2015, 67, 780–789. [Google Scholar] [CrossRef]
- Nara, S.; Mori, A.; Komiya, T. Study on Relative Crystallinity of Moist Potato Starch. Starch–Stärke 1978, 30, 111–114. [Google Scholar] [CrossRef]
- ASTM E96/E96M-22; Standard Test Methods for Gravimetric Determination of Water Vapor Transmission Rate of Materials. American Society for Testing and Materials: West Conshohocken, PA, USA, 2022. [CrossRef]
- ASTM D882-18; Standard Test Method for Tensile Properties of Thin Plastic Sheeting. American Society for Testing and Materials: West Conshohocken, PA, USA, 2019. [CrossRef]
- Muddassir, M.; Raza, A.; Munir, S.; Basirat, A.; Ahmed, M.; Butt, M.S.; Naqvi, S.Z.H. Antibacterial efficacy of silver nanoparticles (AgNPs) against metallo-β-lactamase and extended spectrum β-lactamase producing clinically procured isolates of Pseudomonas aeruginosa. Sci. Rep. 2022, 12, 20685. [Google Scholar] [CrossRef]
- Elshikh, M.; Ahmed, S.; Funston, S.; Dunlop, P.; McGaw, M.; Marchant, R.; Banat, I.M. Resazurin-based 96-well plate microdilution method for the determination of minimum inhibitory concentration of biosurfactants. Biotechnol. Lett. 2016, 38, 1015–1019. [Google Scholar] [CrossRef]
- Alonso, A.M.; Reyes-Maldonado, O.K.; Puebla-Pérez, A.M.; Arreola, M.P.G.; Velasco-Ramírez, S.F.; Zúñiga-Mayo, V.; Velázquez-Juárez, G. GC/MS analysis, antioxidant activity, and antimicrobial effect of Pelargonium peltatum (Geraniaceae). Molecules 2022, 27, 3436. [Google Scholar] [CrossRef]
- Idarraga, G.; Ramos, J.; Zuñiga, V.; Sahin, T.; Young, R.A. Pulp and Paper from Blue Agave Waste from Tequila Production. J. Agric. Food Chem. 1999, 47, 4450–4455. [Google Scholar] [CrossRef]
- Vuorinen, T.V. The role of carbohydrates in alkali anthraquinone pulping. J. Wood Chem. Technol. 1993, 13, 97–125. [Google Scholar] [CrossRef]
- Madzhidova, V.E.; Dalimova, G.N.; Pulatov, B.K. Alkaline hydrolysis of the natural lignin of cottonplant stems in the presence of anthraquinone. Chem. Nat. Compd. 1997, 32, 723–727. [Google Scholar] [CrossRef]
- Berglund, L.; Noël, M.; Aitomäki, Y.; Öman, T.; Oksman, K. Production potential of cellulose nanofibers from industrial residues: Efficiency and nanofiber characteristics. Ind. Crops Prod. 2016, 92, 84–92. [Google Scholar] [CrossRef]
- Wang, Q.Q.; Zhu, J.Y.; Gleisner, R.; Kuster, T.A.; Baxa, U.; McNeil, S.E. Morphological development of cellulose fibrils of a bleached eucalyptus pulp by mechanical fibrillation. Cellulose 2012, 19, 1631–1643. [Google Scholar] [CrossRef]
- Lahtinen, P.; Liukkonen, S.; Pere, J.; Sneck, A.; Kangas, H. A Comparative Study of Fibrillated Fibers from Different Mechanical and Chemical Pulps. BioResources 2014, 9, 2115–2127. Available online: https://ojs.cnr.ncsu.edu/index.php/BioRes/article/view/BioRes_09_2_2115_Lahtinen_Fibrillated_Fibers_Pulps (accessed on 15 May 2023). [CrossRef]
- Zhou, C.; Wu, Q. A novel polyacrylamide nanocomposite hydrogel reinforced with natural chitosan nanofibers. Colloids Surf. B Biointerfaces 2011, 84, 155–162. [Google Scholar] [CrossRef] [PubMed]
- Suopajärvi, T.; Liimatainen, H.; Niinimäki, J. Fragment analysis of different size-reduced lignocellulosic pulps by hydrodynamic fractionation. Cellulose 2012, 19, 237–248. [Google Scholar] [CrossRef]
- Ferrer, A.; Quintana, E.; Filpponen, I.; Solala, I.; Vidal, T.; Rodríguez, A.; Laine, J.; Rojas, O.J. Effect of residual lignin and heteropolysaccharides in nanofibrillar cellulose and nanopaper from wood fibers. Cellulose 2012, 19, 2179–2193. [Google Scholar] [CrossRef]
- Solala, I.; Volperts, A.; Andersone, A.; Dizhbite, T.; Mironova-Ulmane, N.; Vehniäinen, A.; Pere, J.; Vuorinen, T. Mechanoradical formation and its effects on birch kraft pulp during the preparation of nanofibrillated cellulose with Masuko refining. Holzforschung 2012, 66, 477–483. [Google Scholar] [CrossRef]
- Gutiérrez, T.J.; Tapia, M.S.; Pérez, E.; Famá, L. Edible films based on native and phosphated 80:20 waxy:normal corn starch. Starch–Stärke 2015, 67, 90–97. [Google Scholar] [CrossRef]
- Sánchez-González, L.; González-Martínez, C.; Chiralt, A.; Cháfer, M. Physical and antimicrobial properties of chitosan–tea tree essential oil composite films. J. Food Eng. 2010, 98, 443–452. [Google Scholar] [CrossRef]
- Zavareze, E.d.R.; Storck, C.R.; de Castro, L.A.S.; Schirmer, M.A.; Dias, A.R.G. Effect of heat-moisture treatment on rice starch of varying amylose content. Food Chem. 2010, 121, 358–365. [Google Scholar] [CrossRef]
- Araujo-Farro, P.C.; Podadera, G.; Sobral, P.J.A.; Menegalli, F.C. Development of films based on quinoa (Chenopodium quinoa, Willdenow) starch. Carbohydr. Polym. 2010, 81, 839–848. [Google Scholar] [CrossRef]
- Flores, S.; Famá, L.; Rojas, A.M.; Goyanes, S.; Gerschenson, L. Physical properties of tapioca-starch edible films: Influence of filmmaking and potassium sorbate. Food Res. Int. 2007, 40, 257–265. [Google Scholar] [CrossRef]
- Koo, S.H.; Lee, K.Y.; Lee, H.G. Effect of cross-linking on the physicochemical and physiological properties of corn starch. Food Hydrocoll. 2010, 24, 619–625. [Google Scholar] [CrossRef]
- Van Soest, J.J.G.; Hulleman, S.H.D.; De Wit, D.; Vliegenthart, J.F.G. Crystallinity in starch bioplastics. Ind. Crops Prod. 1996, 5, 11–22. [Google Scholar] [CrossRef]
- Balakrishnan, P.; Sreekala, M.S.; Kunaver, M.; Huskić, M.; Thomas, S. Morphology, transport characteristics and viscoelastic polymer chain confinement in nanocomposites based on thermoplastic potato starch and cellulose nanofibers from pineapple leaf. Carbohydr. Polym. 2017, 169, 176–188. [Google Scholar] [CrossRef] [PubMed]
- Kestur, G.S.; Flores-Sahagun, T.H.S.; Dos Santos, L.P.; Dos Santos, J.; Mazzaro, I.; Mikowski, A. Characterization of blue agave bagasse fibers of Mexico. Compos. Part A Appl. Sci. Manuf. 2013, 45, 153–161. [Google Scholar] [CrossRef]
- Montero, B.; Rico, M.; Rodríguez-Llamazares, S.; Barral, L.; Bouza, R. Effect of nanocellulose as a filler on biodegradable thermoplastic starch films from tuber, cereal and legume. Carbohydr. Polym. 2017, 157, 1094–1104. [Google Scholar] [CrossRef]
- Fourati, Y.; Magnin, A.; Putaux, J.L.; Boufi, S. One-step processing of plasticized starch/cellulose nanofibrils nanocomposites via twin-screw extrusion of starch and cellulose fibers. Carbohydr. Polym. 2020, 229, 115554. [Google Scholar] [CrossRef]
- Castaño, J.; Bouza, R.; Rodríguez-Llamazares, S.; Carrasco, C.; Vinicius, R.V.B. Processing and characterization of starch-based materials from pehuen seeds (Araucaria araucana (Mol) K. Koch). Carbohydr. Polym. 2012, 88, 299–307. [Google Scholar] [CrossRef]
- Ma, X.; Chang, P.R.; Yu, J. Plasticized starch. In Starch-Based Polymeric Materials and Nanocomposites: Chemistry, Processing and Applications; Ahmed, J., Tiwari, B.K., Imam, S.H., Rao, M.A., Eds.; CRC Press Taylor & Francis Group, LLC: Boca Ratón, FL, USA, 2012; pp. 69–83. [Google Scholar]
- Ragoubi, M.; Terrié, C.; Leblanc, N. Physico-Chemical, Rheological, and Viscoelastic Properties of Starch Bio-Based Materials. J. Compos. Sci. 2022, 6, 375. [Google Scholar] [CrossRef]
- Merino, D.; Mansilla, A.Y.; Gutiérrez, T.J.; Casalongué, C.A.; Alvarez, V.A. Chitosan coated-phosphorylated starch films: Water interaction, transparency and antibacterial properties. React. Funct. Polym. 2018, 131, 445–453. [Google Scholar] [CrossRef]
- Ghosh Dastidar, T.; Netravali, A. Cross-linked waxy maize starch-based “green” composites. ACS Sustain. Chem. Eng. 2013, 1, 1537–1544. [Google Scholar] [CrossRef]
- Prabhakar, M.N.; Rehman Shah, A.; Song, J.I. Improved flame-retardant and tensile properties of thermoplastic starch/flax fabric green composites. Carbohydr. Polym. 2017, 168, 201–211. [Google Scholar] [CrossRef]
- Xiong, J.; Li, Q.; Shi, Z.; Ye, J. Interactions between wheat starch and cellulose derivatives in short-term retrogradation: Rheology and FTIR study. Food Res Int. 2017, 100, 858–863. [Google Scholar] [CrossRef] [PubMed]
- Rahaman, H.; Hosen, S.; Gafur, A.; Habib, R. Small amounts of poly (d-lactic acid) on the properties of poly (l-lactic acid)/microcrystalline cellulose/poly (d-lactic acid) blends. Results Mater. 2020, 8, 100125. [Google Scholar] [CrossRef]
- Rahaman, M.H.; Islam, M.A.; Islam, M.M.; Rahman, M.A.; Alam, S.N. Biodegradable composite adsorbent of modified cellulose and chitosan to remove heavy metal ions from aqueous solution. Curr. Res. Green Sustain. Chem. 2021, 4, 100119. [Google Scholar] [CrossRef]
- Cao, Y.; Tan, H. Structural characterization of cellulose with enzymatic treatment. J. Mol. Struct. 2004, 705, 189–193. [Google Scholar] [CrossRef]
- Sun, Y.; Lin, L.; Deng, H.; Li, J.; He, B.; Sun, R.; Ouyang, P. Structural changes of bamboo cellulose in formic acid. BioResources 2008, 3, 297–315. [Google Scholar] [CrossRef]
- Wang, L.; Han, G.; Zhang, Y. Comparative study of composition, structure and properties of Apocynum venetum fibers under different pretreatments. Carbohydr. Polym. 2007, 69, 391–397. [Google Scholar] [CrossRef]
- Ghanbari, A.; Tabarsa, T.; Ashori, A.; Shakeri, A.; Mashkour, M. Thermoplastic starch foamed composites reinforced with cellulose nanofibers: Thermal and mechanical properties. Carbohydr. Polym. 2018, 197, 305–311. [Google Scholar] [CrossRef]
- Bergo, P.V.A.; Carvalho, R.A.D.; Sobral, P.J.D.A.; Dos Santos, R.M.C.; Da Silva, F.B.R.; Prison, J.M.; Solorza-Feria, J.; Habitante, A.M.Q.B. Physical properties of edible films based on cassava starch as affected by the plasticizer concentration. Packag. Technol. Sci. Int. J. 2008, 21, 85–89. [Google Scholar] [CrossRef]
- Chen, J.; Wang, X.; Long, Z.; Wang, S.; Zhang, J.; Wang, L. Preparation and performance of thermoplastic starch and microcrystalline cellulose for packaging composites: Extrusion and hot pressing. Int. J. Biol. Macromol. 2020, 165, 2295–2302. [Google Scholar] [CrossRef] [PubMed]
- Liu, P.; Yu, L.; Liu, H.; Chen, L.; Li, L. Glass transition temperature of starch studied by a high-speed DSC. Carbohydr. Polym. 2009, 77, 250–253. [Google Scholar] [CrossRef]
- Liu, P.; Yu, L.; Wang, X.; Li, D.; Chen, L.; Li, X. Glass transition temperature of starches with different amylose/amylopectin ratios. J. Cereal Sci. 2010, 51, 388–391. [Google Scholar] [CrossRef]
- Spence, K.L.; Venditti, R.A.; Habibi, Y.; Rojas, O.J.; Pawlak, J.J. The effect of chemical composition on microfibrillar cellulose films from wood pulps: Mechanical processing and physical properties. Bioresour. Technol. 2010, 101, 5961–5968. [Google Scholar] [CrossRef] [PubMed]
- Behera, A.K.; Avancha, S.; Sen, R.; Adhikari, B. Development and characterization of plasticized starch-based biocomposites with soy pulp as reinforcement filler. J. Appl. Polym. Sci. 2013, 127, 4681–4687. [Google Scholar] [CrossRef]
- Guleria, A.; Singha, A.S.; Rana, R.K. Mechanical, Thermal, Morphological, and Biodegradable Studies of Okra Cellulosic Fiber Reinforced Starch-Based Biocomposites. Adv. Polym. Technol. 2018, 37, 104–112. [Google Scholar] [CrossRef]
- Nascimento, P.; Marim, R.; Carvalho, G.; Mali, S. Nanocellulose produced from rice hulls and its effect on the properties of biodegradable starch films. Mater. Res. 2016, 19, 167–174. [Google Scholar] [CrossRef]
- Wu, R.L.; Wang, X.L.; Li, F.; Li, H.Z.; Wang, Y.Z. Green composite films prepared from cellulose, starch and lignin in room-temperature ionic liquid. Bioresour. Technol. 2009, 100, 2569–2574. [Google Scholar] [CrossRef]
- García, N.L.; Ribba, L.; Dufresne, A.; Aranguren, M.; Goyanes, S. Effect of glycerol on the morphology of nanocomposites made from thermoplastic starch and starch nanocrystals. Carbohydr. Polym. 2011, 84, 203–210. [Google Scholar] [CrossRef]
- Żołek-Tryznowska, Z.; Bednarczyk, E.; Tryznowski, M.; Kobiela, T. A Comparative Investigation of the Surface Properties of Corn-Starch-Microfibrillated Cellulose Composite Films. Materials 2023, 16, 3320. [Google Scholar] [CrossRef] [PubMed]
- Velásquez-Castillo, L.E.; Leite, M.A.; Tisnado, V.J.A.; Ditchfield, C.; Sobral, P.J.D.A.; Moraes, I.C.F. Cassava Starch Films Containing Quinoa Starch Nanocrystals: Physical and Surface Properties. Foods 2023, 12, 576. [Google Scholar] [CrossRef] [PubMed]
- Ghasemlou, M.; Aliheidari, N.; Fahmi, R.; Shojaee-Aliabadi, S.; Keshavarz, B.; Cran, M.J.; Khaksar, R. Physical, mechanical and barrier properties of corn starch films incorporated with plant essential oils. Carbohydr. Polym. 2013, 98, 1117–1126. [Google Scholar] [CrossRef] [PubMed]
- Ekici, G.; Dümen, E. Escherichia coli and food safety. In The Universe of Escherichia coli; Erjavec, M.S., Ed.; Interchopen: London, UK, 2019; Chapter 5; pp. 85–100. [Google Scholar] [CrossRef]
- Yuan, Y.; Chen, H. Preparation and characterization of a biodegradable starch-based antibacterial film containing nanocellulose and polyhexamethylene biguanide. Food Packag. Shelf Life 2021, 30, 100718. [Google Scholar] [CrossRef]
- Lauer, M.K.; Smith, R.C. Recent advances in starch-based films toward food packaging applications: Physicochemical, mechanical, and functional properties. Compr. Rev. Food Sci. Food Saf. 2020, 19, 3031–3083. [Google Scholar] [CrossRef]

| Biocomposite Film | L* | a* | b* | ΔE | Crystallinity (%) | Thickness (mm) | Electrical Conductivity (nA) |
|---|---|---|---|---|---|---|---|
| TPS | 88.22 ± 2.91 | 0.15 ± 0.01 | 2.24 ± 0.06 | --- | 8.8 ± 0.28 | 0.186 ± 0.007 | 10.36 ± 0.24 |
| 2.0 wt% ubCNF | 64.61 ± 1.81 | 1.44 ± 0.03 | 0.57 ± 0.02 | 23.70 ± 1.10 | 6.9 ± 0.14 | 0.222 ± 0.012 | 11.64 ± 0.25 |
| 6.0 wt% ubCNF | 54.23 ± 1.52 | 1.59 ± 0.05 | 0.86 ± 0.02 | 34.05 ± 1.39 | 7.1 ± 0.27 | 0.223 ± 0.008 | 12.20 ± 0.16 |
| 2.0 wt% bCNF | 83.16 ± 2.01 | −0.78 ± 0.03 | 1.65 ± 0.05 | 5.18 ± 0.92 | 5.6 ± 0.31 | 0.212 ± 0.013 | 10.79 ± 0.09 |
| 6.0 wt% bCNF | 75.06 ± 2.48 | 2.63 ± 0.07 | 4.93 ± 0.12 | 13.66 ± 0.44 | 7.4 ± 0.28 | 0.207 ± 0.013 | 10.82 ± 0.07 |
| 2.0 wt% CNC | 72.34 ± 1.74 | 2.55 ± 0.07 | 8.06 ± 0.27 | 17.08 ± 1.19 | 7.2 ± 0.31 | 0.175 ± 0.011 | 11.98 ± 0.11 |
| 6.0 wt% CNC | 68.83 ± 1.93 | 3.98 ± 0.13 | 12.1 ± 0.29 | 22.07 ± 1.02 | 7.6 ± 0.29 | 0.181 ± 0.019 | 12.49 ± 0.20 |
| pA | p < 0.05 | p < 0.05 | p < 0.05 | p < 0.05 | p < 0.05 | p > 0.05 | p < 0.05 |
| pB | p < 0.05 | p < 0.05 | p < 0.05 | p < 0.05 | p < 0.05 | p > 0.05 | p < 0.05 |
| pAB | p < 0.05 | p < 0.05 | p < 0.05 | p < 0.05 | p < 0.05 | p > 0.05 | p < 0.05 |
| Peak Area Ratios. AREAλ/AREAλREF. (λREF: 925, 1077 cm−1) | ||||||||
|---|---|---|---|---|---|---|---|---|
| λ/λREF | Control (TPS) | Composites (2.0 wt%) | Composites (6.0 wt%) | p (Statistical) | ||||
| ubCNF | bCNF | CNC | ubCNF | bCNF | CNC | pA, pB, pA,B a = 0.05 | ||
| 1077/925 | 0.74 ± 0.01 | 0.67 ± 0.005 | 0.67 ± 0.01 | 0.66 ± 0.01 | 0.67 ± 0.02 | 0.66 ± 7 × 10−5 | 0.67 ± 0.02 | p > a, p > a, p < a |
| 861/925 | 0.94 ± 0.04 | 0.93 ± 0.004 | 0.89 ± 0.01 | 0.88 ± 0.004 | 0.89 ± 0.02 | 0.89 ± 0.01 | 0.86 ± 0.006 | p < a, p < a, p < a |
| 2929/925 | 0.825 ± 0.001 | 0.82 ± 0.01 | 0.84 ± 0.01 | 0.81 ± 0.01 | 0.81 ± 0.01 | 0.82 ± 0.01 | 0.86 ± 0.07 | p > a, p > a, p > a |
| 3280/925 | 4.2 ± 0.10 | 4.42 ± 0.01 | 3.89 ± 0.18 | 4.43 ± 0.13 | 4.26 ± 0.04 | 4.05 ± 0.01 | 4.15 ± 0.002 | p > a, p < a, p < a |
| 1573/925 | 0.026 ± 0.01 | 0.08 ± 0.006 | 0.03 ± 0.001 | 0.04 ± 0.004 | 0.09 ± 0.02 | 0.07 ± 7 × 10−4 | 0.05 ± 0.016 | p < a, p < a, p > a |
| 1020/925 | 0.90 ± 0.02 | 1.58 ± 0.04 | 1.02 ± 0.06 | 0.96 ± 0.15 | 1.58 ± 0.1 | 1.16 ± 0.13 | 0.96 ± 0.37 | p > a, p < a, p > a |
| 1341/925 | 0.28 ± 0.06 | 0.25 ± 0.01 | 0.16 ± 0.05 | 0.12 ± 0.009 | 0.13 ± 0.05 | 0.14 ± 0.009 | 0.12 ± 0.007 | p < a, p < a, p > a |
| 1415/925 | 0.26 ± 0.005 | 0.32 ± 0.01 | 0.29 ± 0.03 | 0.27 ± 0.004 | 0.29 ± 0.005 | 0.26 ± 0.001 | 0.25 ± 0.002 | p < a, p < a, p > a |
| 997/925 | 2.30 ± 0.15 | 1.53 ± 0.02 | 2.11 ± 0.01 | 2.31 ± 0.07 | 1.57 ± 0.07 | 1.89 ± 0.15 | 2.37 ± 0.05 | p > a, p < a, p > a |
| 1357/925 | 0.162 ± 0.008 | 0.09 ± 5 × 10−4 | 0.15 ± 0.07 | 0.180 ± 0.01 | 0.097 ± 0.04 | 0.136 ± 0.01 | 0.26 ± 0.01 | p > a, p < a, p > a |
| 1041/925 | 0.79 ± 0.03 | 0.70 ± 0.005 | 0.65 ± 0.04 | 0.76 ± 0.17 | 0.76 ± 0.01 | 0.68 ± 0.02 | 0.96 ± 0.20 | p > a, p > a, p > a |
| 1206/925 | 0.26 ± 0.003 | 0.29 ± 0.01 | 0.25 ± 0.01 | 0.30 ± 5 × 10−4 | 0.28 ± 0.02 | 0.26 ± 0.008 | 0.30 ± 0.003 | p > a, p < a, p > a |
| 1020/1077 | 1.21 ± 0.05 | 2.36 ± 0.07 | 1.53 ± 0.06 | 1.45 ± 0.21 | 2.38 ± 0.20 | 1.76 ± 0.20 | 1.44 ± 0.60 | p > a, p < a, p > a |
| Biocomposite Film | Solubility (%) | Water Vapor Transmission (g/h m2) | Water Vapor Permeance 1010 (g/Pa m s) | Tg1 (°C) | Tg2 (°C) | Ts–Te (°C) | Ash Content (%) | Rugosity (µm) |
|---|---|---|---|---|---|---|---|---|
| Control (TPS) | 50.57 ± 0.85 | 14.69 ± 0.95 | 2.992 ± 0.194 | 67.0 ± 4.0 | 118.7 ± 4.9 | 252–452 | 4.174 | 0.36 ± 0.1 |
| 2.0 wt% ubCNF | 48.71 ± 0.82 | 11.46 ± 0.88 | 2.786 ± 0.214 | 58.9 ± 0.8 | 121.2 ± 2.7 | - | - | 1.56 ± 0.3 |
| 6.0 wt% ubCNF | 47.72 ± 0.86 | 11.13 ± 0.62 | 2.841 ± 0.158 | 65.1 ± 2.3 | 115.3 ± 6.5 | 214–438 | 7.985 | 0.73 ± 0.08 |
| 2.0 wt% bCNF | 47.86 ± 0.83 | 14.40 ± 0.28 | 3.501 ± 0.068 | 73.8 ± 5 | 121.6 ± 1.6 | - | - | 0.72 ± 0.33 |
| 6.0 wt% bCNF | 46.98 ± 0.71 | 12.58 ± 0.42 | 2.990 ± 0.100 | 67.2 ± 4.3 | 117.9 ± 4.2 | 213–422 | 9.392 | 0.89 ± 0.27 |
| 2.0 wt% CNC | 48.42± 0.98 | 12.69 ± 0.17 | 2.434 ± 0.032 | 70.6 ± 1.8 | 119.9 ± 2.6 | - | - | 0.26 ± 0.09 |
| 6.0 wt% CNC | 47.57 ± 0.77 | 11.97 ± 0.08 | 2.373 ± 0.015 | 68.3 ± 2.1 | 118.9 ± 2.7 | 204–452 | 4.222 | 0.15 ± 0.002 |
| pA | p < 0.05 | p < 0.05 | p < 0.05 | p < 0.05 | p < 0.05 | p > 0.05 | ||
| pB | p > 0.05 | p < 0.05 | p < 0.05 | p < 0.05 | p < 0.05 | p > 0.05 | ||
| pAB | p > 0.05 | p > 0.05 | p < 0.05 | p < 0.05 | p < 0.05 | p < 0.05 |
Disclaimer/Publisher’s Note: The statements, opinions and data contained in all publications are solely those of the individual author(s) and contributor(s) and not of MDPI and/or the editor(s). MDPI and/or the editor(s) disclaim responsibility for any injury to people or property resulting from any ideas, methods, instructions or products referred to in the content. |
© 2023 by the authors. Licensee MDPI, Basel, Switzerland. This article is an open access article distributed under the terms and conditions of the Creative Commons Attribution (CC BY) license (https://creativecommons.org/licenses/by/4.0/).
Share and Cite
Lomelí-Ramírez, M.G.; Reyes-Alfaro, B.; Martínez-Salcedo, S.L.; González-Pérez, M.M.; Gallardo-Sánchez, M.A.; Landázuri-Gómez, G.; Vargas-Radillo, J.J.; Diaz-Vidal, T.; Torres-Rendón, J.G.; Macias-Balleza, E.R.; et al. Thermoplastic Starch Biocomposite Films Reinforced with Nanocellulose from Agave tequilana Weber var. Azul Bagasse. Polymers 2023, 15, 3793. https://doi.org/10.3390/polym15183793
Lomelí-Ramírez MG, Reyes-Alfaro B, Martínez-Salcedo SL, González-Pérez MM, Gallardo-Sánchez MA, Landázuri-Gómez G, Vargas-Radillo JJ, Diaz-Vidal T, Torres-Rendón JG, Macias-Balleza ER, et al. Thermoplastic Starch Biocomposite Films Reinforced with Nanocellulose from Agave tequilana Weber var. Azul Bagasse. Polymers. 2023; 15(18):3793. https://doi.org/10.3390/polym15183793
Chicago/Turabian StyleLomelí-Ramírez, María Guadalupe, Benjamín Reyes-Alfaro, Silvia Lizeth Martínez-Salcedo, María Magdalena González-Pérez, Manuel Alberto Gallardo-Sánchez, Gabriel Landázuri-Gómez, J. Jesús Vargas-Radillo, Tania Diaz-Vidal, José Guillermo Torres-Rendón, Emma Rebeca Macias-Balleza, and et al. 2023. "Thermoplastic Starch Biocomposite Films Reinforced with Nanocellulose from Agave tequilana Weber var. Azul Bagasse" Polymers 15, no. 18: 3793. https://doi.org/10.3390/polym15183793
APA StyleLomelí-Ramírez, M. G., Reyes-Alfaro, B., Martínez-Salcedo, S. L., González-Pérez, M. M., Gallardo-Sánchez, M. A., Landázuri-Gómez, G., Vargas-Radillo, J. J., Diaz-Vidal, T., Torres-Rendón, J. G., Macias-Balleza, E. R., & García-Enriquez, S. (2023). Thermoplastic Starch Biocomposite Films Reinforced with Nanocellulose from Agave tequilana Weber var. Azul Bagasse. Polymers, 15(18), 3793. https://doi.org/10.3390/polym15183793

